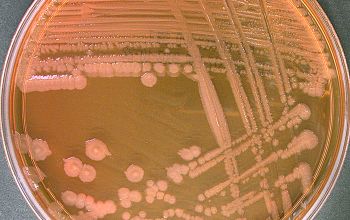

Seventeenth-century German image of Proteus, the Sea God
Proteus is a Greek god of the sea who is capable of changing his form at will.
This association explains the word “protean,” which is used to describe something extremely flexible or ever-changing.
Though this god is not as well-known as some members of the Greek pantheon, he appeared in a few Greek myths, and his name suggests that he may be quite old, given that protos means “first” in Greek.
http://commons.wikimedia.org/wiki/ File:Hoellischer_Proteus.jpg
Proteus vulgaris
-
General information
Taxonomy
Family: Enterobacteriaceae
P.vulgaris
- P.penneri (= P.vulgaris genomosp 1)
- P.hauseri (= P.vulgaris genomosp 3)
Natural habitats
Proteae occur in humans, animals and the environment, especially in locations where animal protein decomposes.
Clinical significance
They were isolated from wounds, soft tissue and urine
P. vulgaris and P. penneri are easily isolated from individuals in long term care facilities and hospitals and from patients with underlying diseases or compromised immune systems.
P. vulgaris is more susceptible to cause nosocomial infections
In people with congenital or anatomic abnormality of the urinary tract or a stone in the urinary tract, are predominantly Proteus (mostly P. mirabilis) infections.
They quickly put this urea into ammonia, which creates an alkaline environment. This can be harmful to the kidney and promotes the formation of stones materials consist of a biochemical complex, which is called struvite. In the stone Proteus bacteria can survive despite therapy, leading to chronic UTI.
-
Gram stain
Gram negative rods,
0.4-0.6 x 1.0-3.0 µm,
ranging in length from coccoid rods to long wire forms.
Proteus spec produce special cells that swarms, these long cells are formed as the cells no longer divide.
-
Culture characteristics
-
Facultative anaerobic
BA: colonies are grey to tan, convex, round, and sometimes they swarm in waves
McConkey: growth non lactose fermenters
BBAØ: growth
Smell: decay / rotting
-
-
Characteristics
-
References
James Versalovic et al.(2011) Manual of Clinical Microbiology 10th Edition
Karen C. Carrol et al (2019) Manual of Clinical Microbiology, 12th Edition